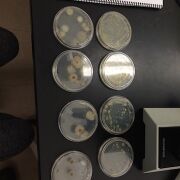

Uploads by Matthew Kelly
From OpenWetWare
Jump to navigationJump to search
This special page shows all uploaded files.
| Date | Name | Thumbnail | Size | Description |
|---|---|---|---|---|
| 19:42, 23 March 2016 | Zb3.jpg (file) |  |
39 KB | |
| 19:41, 23 March 2016 | Zb2.jpg (file) |  |
39 KB | |
| 19:40, 23 March 2016 | Zb1.jpg (file) |  |
42 KB | |
| 19:38, 23 March 2016 | Ob4.jpg (file) |  |
210 KB | |
| 19:38, 23 March 2016 | Ob3.jpg (file) |  |
238 KB | |
| 19:38, 23 March 2016 | Ob2.jpg (file) |  |
238 KB | |
| 19:37, 23 March 2016 | Ob1.jpg (file) |  |
233 KB | |
| 21:05, 16 March 2016 | Web1234.jpg (file) |  |
35 KB | |
| 21:04, 16 March 2016 | Tablevert.jpg (file) |  |
158 KB | |
| 22:38, 24 February 2016 | Invert3.jpg (file) |  |
117 KB | |
| 22:37, 24 February 2016 | Invert1.jpg (file) |  |
160 KB | |
| 22:36, 24 February 2016 | Invert5.jpg (file) |  |
6 KB | |
| 22:36, 24 February 2016 | Invert2.jpg (file) |  |
9 KB | |
| 22:35, 24 February 2016 | Invert4.jpg (file) |  |
141 KB | |
| 22:35, 24 February 2016 | Invertibratetable.jpg (file) | 86 KB | ||
| 22:33, 24 February 2016 | Tunnnele.jpg (file) |  |
18 KB | |
| 20:03, 10 February 2016 | Shrub123.jpg (file) |  |
53 KB | |
| 20:03, 10 February 2016 | Grass123.jpg (file) |  |
47 KB | |
| 20:02, 10 February 2016 | Fernspore.jpg (file) |  |
43 KB | |
| 20:02, 10 February 2016 | Fern123.jpg (file) |  |
70 KB | |
| 20:01, 10 February 2016 | Tree123.jpg (file) |  |
67 KB | |
| 20:01, 10 February 2016 | Ivy123.jpg (file) |  |
55 KB | |
| 19:39, 10 February 2016 | Table3.1.jpg (file) | 136 KB | ||
| 21:55, 5 February 2016 | Agar-9Example.jpg (file) |  |
41 KB | |
| 21:54, 5 February 2016 | Agar-5Example.jpg (file) |  |
46 KB | |
| 21:53, 5 February 2016 | Tet-5Example.jpg (file) |  |
68 KB | |
| 21:51, 5 February 2016 | Tet-9Example.jpg (file) |  |
37 KB | |
| 21:49, 5 February 2016 | Agar-5b4Example.jpg (file) |  |
29 KB | |
| 21:48, 5 February 2016 | Agar-9b4Example.jpg (file) |  |
48 KB | |
| 21:47, 5 February 2016 | Tet-5b4Example.jpg (file) |  |
99 KB | |
| 21:45, 5 February 2016 | Tet-9b4Example.jpg (file) |  |
45 KB | |
| 20:08, 5 February 2016 | AgarplatesExample.jpg (file) | |
51 KB | |
| 19:50, 5 February 2016 | Table2.1.jpg (file) |  |
20 KB | |
| 19:39, 5 February 2016 | Table2.2.jpg (file) |  |
33 KB | |
| 00:00, 5 February 2016 | Paramecium123.JPG (file) |  |
86 KB | |
| 23:58, 4 February 2016 | Chilomonas123.JPG (file) |  |
51 KB | |
| 23:57, 4 February 2016 | Blepharisma123.JPG (file) |  |
28 KB | |
| 23:47, 4 February 2016 | Hayinfusion123.jpg (file) |  |
33 KB | |
| 20:00, 27 January 2016 | Section2.jpg (file) |  |
137 KB |